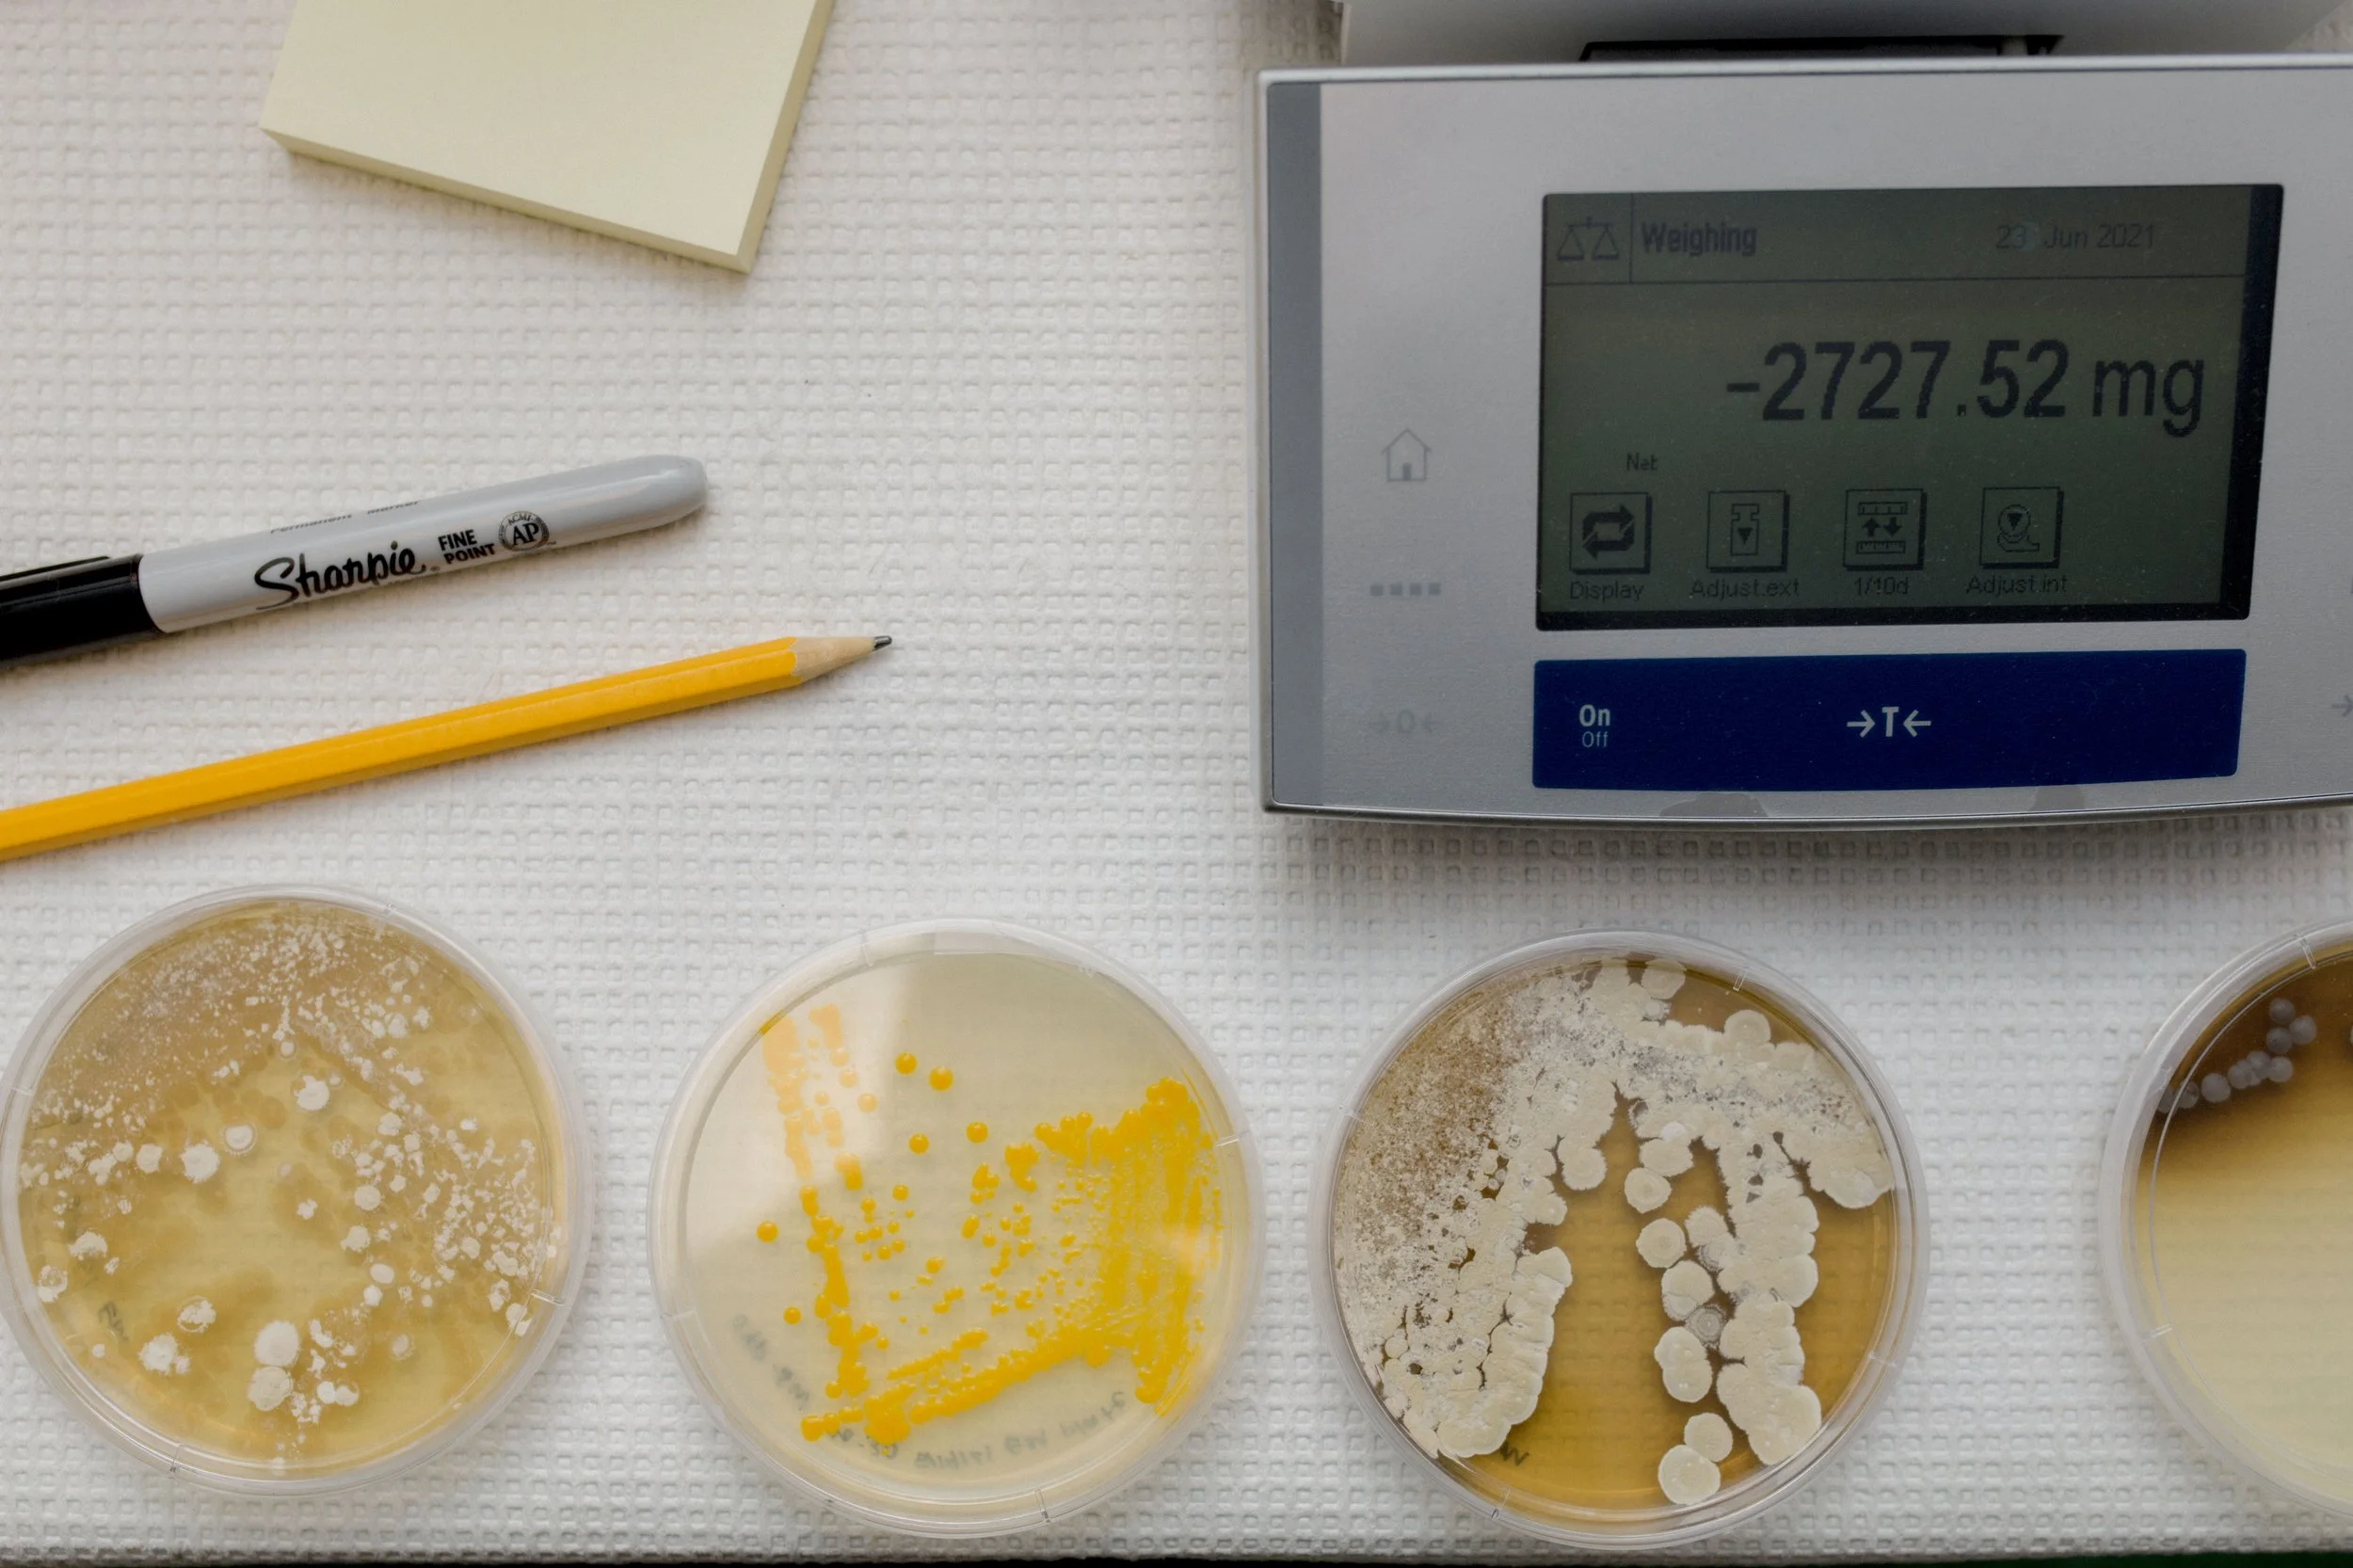

University of Florida















University of Florida